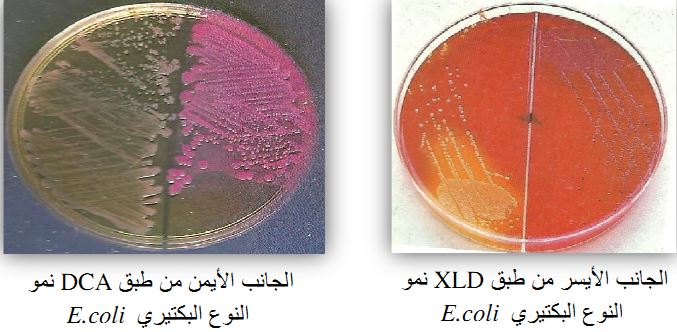

النبات
النبات
 الحيوان
الحيوان
 الأحياء المجهرية
الأحياء المجهرية
 علم الأمراض
علم الأمراض
 التقانة الإحيائية
التقانة الإحيائية
 التقنية الحيوية المكروبية
التقنية الحيوية المكروبية
 التقنية الحياتية النانوية
التقنية الحياتية النانوية
 علم الأجنة
علم الأجنة
 الأحياء الجزيئي
الأحياء الجزيئي
 علم وظائف الأعضاء
علم وظائف الأعضاء
 الغدد
الغدد
 المضادات الحيوية
المضادات الحيوية|
أقرأ أيضاً
التاريخ: 17-7-2019
التاريخ: 6-3-2016
التاريخ: 4-11-2018
التاريخ: 13-3-2016
|
Escherichia coli
وهي عبارة عن خلايا بكتيرية سالبة لصبغة جرام غير مكونة للأبواغ ومتحركة لإحتوائها على أسواط متعددة وحافظة أو حافظة دقيقة microcapsule تكسبها اللزوجة عند تنميتها على الوسط الغذائي المناسب.
كما أنها لا هوائية اختيارياً ولها القدرة على تخمير الكربوهيدرات منتجة غاز، خلاياها عصوية يتراوح حجمها حوالي 6.0 – 2.0 ميكرو متر طولا وحوالي 1.1 – 1.5 عرضاً، كما أن الشكل الظاهري للخلايا قد يكون كروياً أو عصيات خيطية طويلة. السلالات المكونة للحافظة لها القدرة على انتاج مستضد خارجي يعرف بمستضد K ومستضد M. ولهذا النوع البكتيري أهذاب تساعده على الإلتصاق بخلايا العائل وهذه الأهذاب تختلف من حيث التركيب في السلالات المختلفة للنوع البكتيري Escherichia coli . تم التعرف على هذا النوع البكتيري سنة 1885 وسمي آنذاك بــ Bacterium coli commune واستمر تداول هذا الإسم حتى سنة 1919 عندما تم تعديل الاسم ليصبح Escherichia ، وبدأ في أربعينات القرن الماضي التعرف على أنواع هذا النوع البكتيري المختلفة وتصنيفها إلى اكثر من 70 مجموعة مصلية مختلفة اعتماداً على المستضد (O antigen) ، وفي الوقت الحالي اضيف إليها أكثر من 50 نوع اعتماداً على المستضد (H antigen) وأكثر من 100 نوع بناءاً على المستضد (K antigen) . تظهر الاختبارات الكيموحيوية أن لهذا النوع البكتيري القدرة على انتاج الغاز عند تخمره لسكر اللاكتوز كما له القدرة على انتاج الأندول والقدرة على إحلال اليوريا كما أنه يعطي نتيجة سالبة التفاعل لاختبار انتاج كبريتيد الهيدروجين عند تنميته على الوسط الغذائي Triple sugar Iron Agar(TSI) . وليس لهذا النوع البكتيري القدرة على إمانة الجيلاتين كما أنه قادر على النمو في الوسط الغذائي Simmon's citrate agar (SCA) وهو المسئول عن تفشي أغلب حالات الإسهال خلال فصل الصيغ وبعض حالات الإسهال عند الأطفال وحالات التسمم الغذائي ، ويتواجد هذا النوع البكتيري بصورة طبيعية كفلورة طبيعية في أمعاء الإنسان والحيوان ، وفي بعض الأحيان يتحول إلى بكتيريا ممرضة مسبباً بعض الإصابات ، فهو على سبيل المثال المسبب الرئيسي لإلتهابات الجهاز البولي الحادة والمزمنة.

مستعمرات النوع البكتيري Escherichia coliبصبغة جرام
الامراضية :
هناك العديد من السلالات التابعة لهذا النوع البكتيري والتي لها القدرة على إحداث الإسهال كالتالي :
ــ ETEC (Enterotoxigenic E. coli )
هذه السلالة البكتيرية تسبب الإسهال المائي watery diarrhoeae عند الأطفال والبالغين في المناطق النائية ، وذلك نتيجة لإفرازها ذيفانات مقاومة للحرارة heat stable (ST) واخرى حساسة للحرارة heat labile (LT) ، وهذا الإسهال يعرب بإسهال المسافرين . وهناك العديد من المجموعات المصلية من هذه السلالة البكتيرية. من خلال الدراسات التي أجريت تبين أن الجرعة الممرضة اللازمة لإحداث المرض تختلف حسب السلالة البكتيرية فالإصابة بهذه السلالة البكتيرية فإن الجرعة الممرضة تبلغ حوالي 108 - 1010 خلية بكتيرية.
ــ EPEC (Enterotoxigenic E. coli ) :
تعتبر هذه السلالة البكتيرية من أهم مسببات الإصابة في المناطق النائية وتكون الجرعة الممرضة اللازمة لإحداث الإصابة بهذه السلالة البكتيرية بتركيز يتراوح ما بين 105 - 1010 خلية بكتيرية ، وتتسم الإصابة بظهور الأعراض المتمثلة في القيء، حمى وإسهال لفترة طويلة خاصة في الأطفال الذين تقل أعمارهم عن سنتين وذلك نتيجة لإلتصاق المستعمرات البكتيرية بخلايا النسيج الظهاري epithelial cells وهو ما أدى لأن يطلق على هذه السلالة البكتيرية بــ diffusely adherent E.coli (DAEC) ، حيث تتضاعف مكونة لطخة lesion، وهناك العديد من المجموعات المصلية من هذه السلالة البكتيرية.
ــ EIEC (Enteroivasive E. coli) :
هذه السلالة البكتيرية تسبب مرض الزحار dysentery وهو يشبه الإسهال الذي يسببه الجنس البكتيري Shigella Spp ومن أعراضه ظهور الحمى والتهاب القولون colitis مع وجود دم ومخاط وكذلك العديد من الخلايا الصديدية pus cells في عينة البزاز وذلك نتيجة لأن هذه السلالة لها القدرة على التضاعف داخل خلايا النسيج الظهاري ، وهناك العديد من المجموعات المصلية من هذه السلالة البكتيرية . كما تسبب هذه السلالة البكتيرية التهاب السحايا في الأطفال حيث أنه يصاب طفل من بين 2000 طفل بهذا المرض، ووجد أن 80% من هذه السلالة يكون مستضد الحافظة من النوع K – 1 الذي يعتبر العامل الافتراضي المسبب لإلتهاب السحايا في المواليد، من خلال الدراسات الوبائية تبين أن هذه السلالة تتواجد بشكل كبير في النساء الحوامل مما قد يؤدي لإصابة المواليد حيث تغزو هذه السلالة مجرى الدم من خلال البلعوم الانفي كما أنها قد تتواجد في الجهاز الهظمي لتصل إلى السحايا meninges.
ــ EHEC (Enterohaemorrhagic E. coli :
هذه السلالة البكتيرية تسبب داء التهاب القولون المدمي hemorrhagic colitis (HC) في مختلف الأعمار بدون تكوين الخلايا الصديدية pus cells وبدون ظهور حمى ، وهو ما يعرف بالإسهال المدمي نتيجة لإفراز هذه السلالة البكتيرية ذيفانات تعرف بـ verotoxin or Shiga toxins (Stx) ، ويكفي فقط أقل من 100 مستعمرة بكتيرية لإحداث الإصابة بالتالي فهي من اهم سلالات النوع البكتيري E. coli كما يمكن لهذه السلالة البكتيرية إحداث الإصابات في المسالك البولية مثل haemolytic uraemic syndrome مع فشل كلوي . تم تسجيل العديد من الجانحات في مراكز إيوان اللاجئين في موزمبيق وسوازيلاندا ومالاوي ويحدث الإسهال المدمي نتيجة إفراز هذه السلالة البكتيرية للذيفانات المدمر للخلايا cytotoxins التي تتلف الخلايا الوعائية للنسيج الظهاري ومن همها المجموعة البكتيرية O157 : H7 كما أنها تعرف بــ verocytoxin producing E. coli (VTEC) ، حيث إنها تؤثر على الخلايا vero للقرود في الاختبارات المعملية ، وغالباً ما تحدث الإصابة نتيجة تناول الأغذية الملوثة مثل اللحوم ومشتقاتها والحليب غير المبستر ومشتقاته.

ــ EaggEC (Enteroaggregative E. coli)
وهذه السلالة البكتيرية نسبب الإسهال المائي المزمن Chronic watery diarrhoeae والقيء خاصة في الأطفال وذلك نتيجة لألتصاقها بخلايا الأنسجة مما يجعلها متلاصقة (aggregates) وهي المسئولة على إصابات الإسهال في الأطفال وهذه السلالة تشبه سلالة ETEC التي تلتصق بالغشاء المخاطي للأمعاء مسببة إسهال غير مدمي وبدون إحداث أي التهابات تفرز هذه السلالة الذيفان المعوي enterotoxin كما تنتج الإنزيم المحلل لكرياتا لدم الحمراء haemolysin الذي له نفس خصائص الإنزيم الموجود في السلالات المسببة لألتهابات الجهاز البولي، والجدل ما زال مستمراً حول دور هذه السلالة في إحداث الإصابات البشرية.
التشخيص المعملي :
يعتمد نوع العينة التي قيد الاختبار المعملي على نوعية الإصابة ، فقد يتم تجميع عينة بول urine أو صديد pus أو براز faeces أو دم blood أو سائل النخاع الشوكي cerebrospinal fluid لإجراء المزرعة البكتيري او الفحص المجهري او الاختيارات المصلية. أغلب سلالات هذا النوع البكتيري لها القدرة على النمو في درجات حرارة 44-18 درجة مئوية.
ــ الوسط الغذائي blood agar :

النوع البكتيري E. coli على الوسط الغذائي Blood agar
يكون هذا النوع البكتيري مستعمرات بكتيرية يقطر 4-1 مليمتر بعد تحضينها لمدة 24 ساعة في درجة حرارة 37 درجة مئوية حيث يكون شكل المستعمرات البكتيرية النامية لزج mucoid وبعض السلالات تظهر إحلال لكريات الدم الحمراء haemolysis.
ــ الوسط الغذائي MacConkey agar والوسط الغذائي CLED :

ــ الوسط الغذائي EMB agar :

النوع البكتيري E. coli على الوسط الغذائي EMB agar
المستعمرات البكتيرية تكون بلون أزرق مسود وعلى هيئة (عين الثور) bulleyes وقد تكون غشاء أخضر لماع.
ــ الوسط الغذائي Sorbitol MacConkey agar : النوع البكتيري E. coli من السلالة VTEC والمعروفة بــ O157 ليس لها القدرة على تخمير سكر السوربيتول Sorbitol منتجة مستعمرات بكتيرية شفافة ، كما أن هناك العديد من السلالات الأخرى لهذا النوع البكتيري والبكتيريا المعوية enterobacteria لها القدرة على تخمير سكر السوربيتول ، ولذلك لابد من إجراء عدة اختبارات إضافية للتعرف على السلالة البكتيرية (VTEC) مثل استعمال O157 latex reaent .

النوع البكتيري E. coli على الوسط الغذائي Sorbitol MacConkey agar
ــ الوسط الغذائي XLD agar والوسط الغذائي DCA agar :
تكون المستعمرات البكتيرية النامية على الوسط الغذائي XLD agar صفراء اللون بينما الوسط الغذائي DCA agar سيظهر نمو المستعمرات البكتيرية للنوع البكتيري E. coli بلون وردي.
ــ الوسط الغذائي Endo agar : تظهر المستعمرات البكتيرية النامية بلون أحمر غامق مع تكون غشاء ذهبي لماع gold metallic sheen

النوع البكتيري E. coli على الوسط الغذائي Endo agar
ــ الوسط الغذائي (Kliger iron agar)KlA: أغلب سلالات النوع البكتيري E. coli تنتج حمض في قاع الإنبوبة (لأون أصفر) وكذلك حمض في الجزء الاعلى slope مما يجعل لون الوسط الغذائي أصفر مع إنتاج الغاز وغياب اللون الأسود لعدم تكون هيدروجين الكبريتيد H2S .
الاختبارات المعملية :
ــ اختبار الإندول : موجب في أغلب سلالات النوع البكتيري E. coli.
ــ اختبار الكشف على إنزيم Lysin decarboxylase (LDC) : موجب
ــ اختبار الكشف على إنزيم Beta – glucuroidase (PGUA) : أغلب السلالات التابعة للنوع البكتيري E. Coli تعطي نتيجة موجبة ، ما عدا السلالة المعروفة بـ O157 فهي تعطي نتيجة سالبة.
ــ اختبار اختزال النترات إلى نيترايت (urine nitrite test) : موجب .
ــ اختبار الكشف على citrate وكبريتيد الهيدروجين H2S.
بعد سلالات النوع البكتيري E.coli تظهر نتيجة سالبة لبعض التفاعلات الكيموحيوية وبذلك فهي تشبه نتيجة اختبارات الجنس البكتيري Shigella Spp. حيث تكون غير متحركة وغير مخمرة لسكر اللاكتوز مع عدم قدرتها على انتاج الغاز.



|
|
|
|
التوتر والسرطان.. علماء يحذرون من "صلة خطيرة"
|
|
|
|
|
|
|
مرآة السيارة: مدى دقة عكسها للصورة الصحيحة
|
|
|
|
|
|
|
نحو شراكة وطنية متكاملة.. الأمين العام للعتبة الحسينية يبحث مع وكيل وزارة الخارجية آفاق التعاون المؤسسي
|
|
|